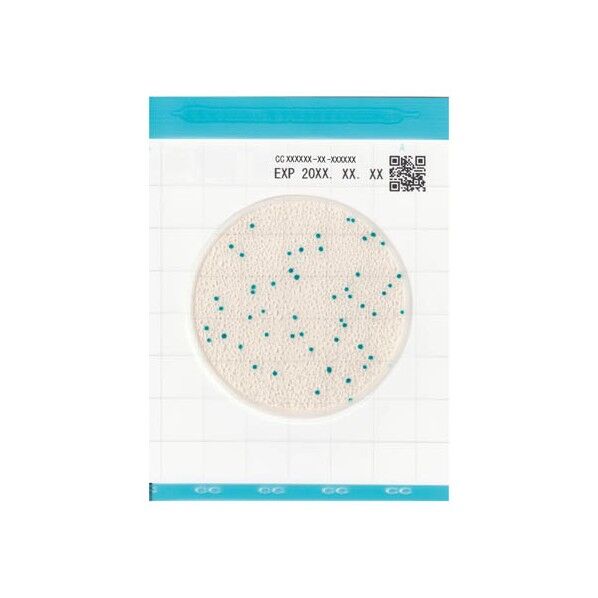
微生物検査用フィルム培地 Easy Plate(Medi・Ca)

キッコーマンの日用品
- ブランド: キッコーマン
- すべて解除する
-
55,900円 (税込)7営業日1種類の商品があります7営業日
-
16,900円 (税込)4営業日1種類の商品があります4営業日
-
51,900円 (税込)7営業日1種類の商品があります7営業日
-
16,900円 (税込)4営業日1種類の商品があります4営業日
-
19,900円 (税込)4営業日1種類の商品があります4営業日
-
62,900円 (税込)7営業日1種類の商品があります7営業日
-
28,900円 (税込)7営業日1種類の商品があります7営業日
-
38,900円 (税込)7営業日1種類の商品があります7営業日
-
17,900円 (税込)廃番1種類の商品があります廃番
-
63,900円 (税込)7営業日1種類の商品があります7営業日
-
55,900円 (税込)7営業日1種類の商品があります
-
キッコーマン ルシパック A3 Surface 4016,900円 (税込)
●ルミテスターPD-20/30用の拭き取り検査試薬です。 ●ATP+ADP+AMP拭き取り検査(A3法)により、より高感度な測定が可能です。 ●洗浄不良をその場でチェックすることができ、食品工場や給食施設の洗浄度管理、医療現場の洗浄度管理・衛生教育に最適です。 ※保存:要冷蔵(2~8℃) ●入数:20本×2袋 ●対応機種:PD-30/20 ●保存:要冷蔵(2~8℃)【入数】 40本...
16,900円 (税込)4営業日1種類の商品があります -
キッコーマン 微生物検査用フィルム培地 Easy Plate(Medi・Ca)59,900円~ (税込)
●袋から出してすぐに使える調製済みのフィルム培地です。 ●混釈や重層といった操作や特別な治具が不要なので、作業時間が短縮できます。 ●重ねながら滴下ができるため、作業時間だけでなく、作業スペースの削減が可能です。 ●発色剤により判別が容易なため、検査初心者でも安心して使えます。 ●入数:1キット(25枚×4袋)×5 ●保存温度:冷蔵(2~8℃) ●規格:AOACPTM認証取得 ●培養温度:35±1℃ 37±1℃ ●培養時間:24±1時間【入数】 500枚...
-
51,900円 (税込)7営業日1種類の商品があります
-
キッコーマン ルシスワブES 60355 40袋18,900円~ (税込)
キッコーマン ルシスワブES 60355 40袋●消化器内視鏡のチャンネルの内部全体をふき取ることができる全長スワブです。●ルシパックA3/ルシパックPenシリーズとセットで使用する専用のオプション品です。●清浄度を数値で確認できますので履歴管理にお役立て頂けます。●用手洗浄(ブラッシング)の直後、洗浄消毒器使用前の測定にお勧めです。●内視鏡チャンネル径(mm):Φ2.0~2.2●全長(mm):2500●入数:1箱(1本入袋×40袋)●重量:約445g●材質:綿●※綿棒が外れたり詰まる恐れがありますので綿球径よりも狭い箇所の検査には使用できません。特徴60355...
-
キッコーマン ルシパックPen4016,900円 (税込)
●ルミテスターPD-20/30専用の拭き取り検査試薬です。 ※保存:要冷蔵(2~8℃) ●入数:20本×2袋 ●対応機種:PD-30/20 ●保存:要冷蔵(2~8℃)【入数】 40本...
16,900円 (税込)4営業日1種類の商品があります -
キッコーマン 微生物検査用フィルム培地 Easy Plate(Medi・Ca)19,900円 (税込)
●袋から出してすぐに使える調製済みのフィルム培地です。 ●混釈や重層といった操作や特別な治具が不要なので、作業時間が短縮できます。 ●重ねながら滴下ができるため、作業時間だけでなく、作業スペースの削減が可能です。 ●発色剤により判別が容易なため、検査初心者でも安心して使えます。 ●真菌(カビ・酵母)のコロニーは紫色を呈します。 入数:1キット(25枚×4袋)×1 保存温度:冷蔵(2~8℃) 規格:AOAC...
19,900円 (税込)4営業日1種類の商品があります -
62,900円 (税込)7営業日1種類の商品があります
-
キッコーマン ルシパックA3 Surface(湿潤綿棒)28,900円 (税込)
●ATPだけではなく、ADP、AMPを検出できる高感度タイプのATPふき取り検査(A3法)の試薬です。 あらかじめ湿潤された綿棒、試薬を含む一体型の検査試薬です。 ●AOAC-RIのPTM認証を取得しています(ライセンスNo.112201)。 保存条件:2~8℃(凍結しないこと) 品質保持期限:製造日より8ヶ月 【入数】 100本...
28,900円 (税込)7営業日1種類の商品があります -
キッコーマン 醸造分析キット38,900円 (税込)
●米麹中の酵素活性を簡単かつ迅速に測定できる分析キットです。 ●液状試薬ですので、そのまま使用できます。 ●共存物質の影響を受けないので、試料溶液の透析が必要がありません。 測定対象:α-アミラーゼ活性 構成内容:基質溶液(60mL) 酵素溶液(60mL) 反応停止液(120mL×2) 使用期限:製造から18ヵ月 【入数】 120回分...
38,900円 (税込)7営業日1種類の商品があります -
キッコーマン 微生物検査用フィルム培地 Easy Plate(Medi・Ca)17,900円 (税込)
●袋から出してすぐに使える調製済みのフィルム培地です。 ●混釈や重層といった操作や特別な治具が不要なので、作業時間が短縮できます。 ●重ねながら滴下ができるため、作業時間だけでなく、作業スペースの削減が可能です。 ●発色剤により判別が容易なため、検査初心者でも安心して使えます。 ●腸内細菌科菌群のコロニーは、赤紫~赤色を呈します。 入数:1キット(25枚×4袋)×1 保存温度:冷蔵(2~8℃) 規格:AO...
17,900円 (税込)廃番1種類の商品があります -
キッコーマン 微生物検査用フィルム培地 Easy Plate(Medi・Ca)63,900円 (税込)
●袋から出してすぐに使える調製済みのフィルム培地です。 ●混釈や重層といった操作や特別な治具が不要なので、作業時間が短縮できます。 ●重ねながら滴下ができるため、作業時間だけでなく、作業スペースの削減が可能です。 ●発色剤により判別が容易なため、検査初心者でも安心して使えます。 ●腸内細菌科菌群のコロニーは、赤紫~赤色を呈します。 入数:1キット(25枚×4袋)×5 保存温度:冷蔵(2~8℃) 規格:AO...
63,900円 (税込)7営業日1種類の商品があります
13件(1~13件)